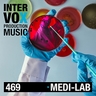
Overtech album cover

[ivox469] Overtech
02:11
File name:ivox469_13_Overtech_537626.mp3
Album:Medi-Lab
Genre:Filmscore, Electronica
Labels:Intervox Production Music
Vocals:No
BPM:70
Explicit:No
Version:Full
Composers:Gillian Gordon (50.0%)
Tempo:Medium-slow
Publisher:Intervox Edition
ISRC:DEKU72046913
PRS:401979AN
Instrumentation:Strings, Guitar, Percussion, Electronic Mallets
Mood:Neutral, Sophisticated, Edgy, Waiting, Melancholic
Description:Percussive Underscore, longing strings, mallets, observing
Album category:Science // Research, Communication // Media
Track category:Science // Research, Art // Design, Documentary
NameIntervox Edition
PRO / MROGEMA undefined
IPI417104790
RolePublisher (50.0%)
Alternate Versions of this Track: